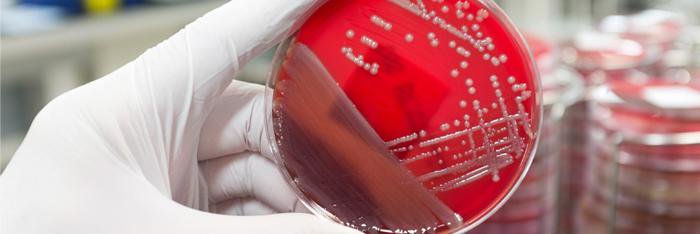
ACCP INFD PRN banner

ACCP INFD PRN
7.3K posts

@accpinfdprn
American College of Clinical Pharmacy Infectious Diseases Practice and Research Network of nearly 2500 members. https://t.co/FgNX81Tp1b



Time to revisit empiric atypical coverage in non-severe CAP? 🆕⚡🔴Target trial emulation using a propensity-weighted cohort from 68 hospitals in Michigan >66,000 patients: • No difference in time to clinical stability • No difference in ICU transfer or antibiotic duration • No difference in 30-day mortality • But ↓ composite 30-day mortality/rehospitalization with azithromycin Signal… or bias?” academic.oup.com/cid/article-ab…





⚡🔥🟢The iNAAN study Direct Oral Challenge for Penicillin Allergy: The International Network of Antibiotic Allergy Nations (iNAAN) Study In this type 2 hybrid effectiveness implementation study that included 5121 adult inpatients in 40 hospitals across 8 countries, multidisciplinary-led inpatient penicillin direct oral challenge was safe (95.5% delabeled) and effective, with significant improvements in antibiotic prescribing post evaluation #IDXposts academic.oup.com/cid/article/do…
















